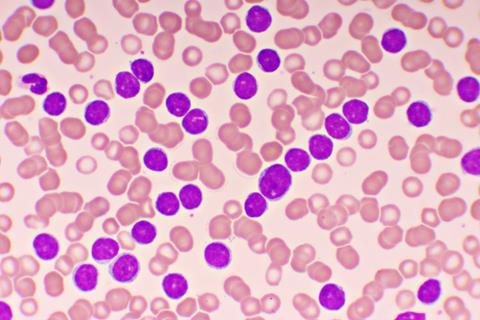
Image

Janssen states Imbruvica® plus venetoclax will provide "a much-needed new treatment option" for chronic lymphocytic leukaemia.
Imbruvica® (ibrutinib) plus venetoclax has been recommended as an option for untreated chronic lymphocytic leukaemia (CLL) in adults by the National Institute for Health and Care Excellence (NICE).
Ibrutinib is a tyrosine kinase inhibitor (TKI) therapy. By blocking Bruton’s tyrosine kinase (BTK), which is needed by cancer cells to multiply and spread, ibrutinib could help stop them from growing and dividing.
Impact of NICE’s recommendation of ibrutinib plus venetoclax
“We are delighted with NICE’s decision to recommend [anti-cancer therapeutic] ibrutinib plus venetoclax, especially since it has been recommended for use in the entire indicated population in England,” commented Amanda Cunnington, Director of Patient Access for Janssen-Cilag Limited.
"[ibrutinib plus venetoclax] has been recommended for use in the entire indicated population in England"
"This is a great step forward in the treatment of CLL," stated Hilary Lindsay, Chair of CLL Support.
“The availability of this combination therapy will bring a much-needed new treatment option for those living with CLL, and Janssen is proud to have added to our existing ibrutinib-based treatment options for patients across England and Wales,” Cunnington added.
At present, Imbruvica is indicated in Great Britain as:
- A single agent for adults with relapsed or refractory mantle cell lymphoma (MCL)
- A single agent or together with rituximab or obinutuzumab or venetoclax for adults with previously untreated CLL
- A single agent or with bendamustine and rituximab (BR) for adult patients with CLL who have received at least one prior therapy
- A single agent for the treatment of adult patients with Waldenström's macroglobulinaemia (WM) who have received at least one prior therapy, or in first line treatment for patients unsuitable for chemo-immunotherapy. Imbruvica in combination with rituximab is indicated for the treatment of adult patients with WM.
Chronic lymphocytic leukaemia
CLL is a condition that affects white blood cells and bone marrow in the body. According to charity group CLL Support, it is the most common type of leukaemia in adults. In CLL, a blood cancer, around 3,800 people are diagnosed in the UK each year.
Topics
- Amanda Cunnington
- Anti-Cancer Therapeutics
- Bioprocessing and biomanufacturing
- Chronic lymphocytic leukaemia (CLL)
- Drug Development
- Formulation and drug delivery
- Janssen
- National Institute for Health and Clinical Excellence (NICE)
- Pharmacovigilance and safety oversight
- Regulation and compliance
- Therapeutics
- venetoclax


